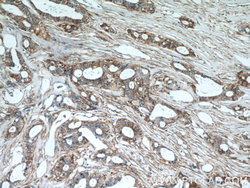

Antibody data
- Antibody Data
- Antigen structure
- References [69]
- Comments [0]
- Validations
- Western blot [1]
- Immunocytochemistry [1]
- Immunohistochemistry [2]
Submit
Validation data
Reference
Comment
Report error
- Product number
- 22787-1-AP - Provider product page

- Provider
- Proteintech Group
- Proper citation
- Proteintech Cat#22787-1-AP, RRID:AB_11182479
- Product name
- MCT4 antibody
- Antibody type
- Polyclonal
- Description
- KD/KO validated MCT4 antibody (Cat. #22787-1-AP) is a rabbit polyclonal antibody that shows reactivity with human, rat and has been validated for the following applications: FC, IF, IHC, WB,ELISA.
- Reactivity
- Human, Rat
- Host
- Rabbit
- Conjugate
- Unconjugated
- Isotype
- IgG
- Vial size
- 20ul, 150ul
Submitted references Monocarboxylate Transporters 1 and 2 Are Responsible for L-Lactate Uptake in Differentiated Human Neuroblastoma SH-SY5Y Cells.
Serine synthesis pathway upregulated by E-cadherin is essential for the proliferation and metastasis of breast cancers.
MCT4-dependent lactate transport: a novel mechanism for cardiac energy metabolism injury and inflammation in type 2 diabetes mellitus.
Real-time monitoring of glucose metabolism and effects of metformin on HepG2 cells using (13)C in-cell NMR spectroscopy.
Exercise enhances placental labyrinth trophoblast development by activation of PGC-1α and FNDC5/irisin†.
Monocarboxylate transporter 4 deficiency enhances high-intensity interval training-induced metabolic adaptations in skeletal muscle.
The SIX1/LDHA Axis Promotes Lactate Accumulation and Leads to NK Cell Dysfunction in Pancreatic Cancer.
Loss of Lactate/Proton Monocarboxylate Transporter 4 Induces Ferroptosis via the AMPK/ACC Pathway and Inhibition of Autophagy on Human Bladder Cancer 5637 Cell Line.
Acidification of intracellular pH in MM tumor cells overcomes resistance to hypoxia-mediated apoptosis in vitro and in vivo.
Oral administration of procyanidin B2 3,3"-di-O-gallate ameliorates experimental autoimmune encephalomyelitis through immunosuppressive effects on CD4(+) T cells by regulating glycolysis.
Icariin-Curcumol promotes docetaxel sensitivity in prostate cancer through modulation of the PI3K-Akt signaling pathway and the Warburg effect.
Chemoproteomics reveals microbiota-derived aromatic monoamine agonists for GPRC5A.
SETDB1 Methylates MCT1 Promoting Tumor Progression by Enhancing the Lactate Shuttle.
Post-ischemic inactivation of HIF prolyl hydroxylases in endothelium promotes maladaptive kidney repair by inducing glycolysis.
Evodiamine impairs HIF1A histone lactylation to inhibit Sema3A-mediated angiogenesis and PD-L1 by inducing ferroptosis in prostate cancer.
SLC16a6, mTORC1, and Autophagy Regulate Ketone Body Excretion in the Intestinal Cells.
NPAS2 promotes aerobic glycolysis and tumor growth in prostate cancer through HIF-1A signaling.
An independent regulator of global release pathways in astrocytes generates a subtype of extracellular vesicles required for postsynaptic function.
Nicotine activates HIF-1α and regulates acid extruders through the nicotinic acetylcholine receptor to promote the Warburg effect in non-small cell lung cancer cells.
Enhanced autophagy reversed aflatoxin B1-induced decrease in lactate secretion of dairy goat Sertoli cells.
Lactylome analysis suggests lactylation-dependent mechanisms of metabolic adaptation in hepatocellular carcinoma.
Lactate metabolism is essential in early-onset mitochondrial myopathy.
Monocarboxylate transporter 4 involves in energy metabolism and drug sensitivity in hypoxia.
Immunohistochemical evaluation and prognostic value of monocarboxylate transporter 1 (MCT1) and 4 (MCT4) in T-cell non-Hodgkin lymphoma.
Functional heterogeneity of MCT1 and MCT4 in metabolic reprogramming affects osteosarcoma growth and metastasis.
Fibroblast growth factor 21 protects the liver from apoptosis in a type 1 diabetes mouse model via regulating L-lactate homeostasis.
Bacterial butyrate mediates the anti-atherosclerotic effect of silybin.
Circ_0000235 targets MCT4 to promote glycolysis and progression of bladder cancer by sponging miR-330-5p.
Shoutai Wan regulates glycolysis imbalance at the maternal-fetal interface in threatened abortion mice.
Shoutai Wan Improves Embryo Survival by Regulating Aerobic Glycolysis of Trophoblast Cells in a Mouse Model of Recurrent Spontaneous Abortion.
Trophoblast-derived Lactic Acid Orchestrates Decidual Macrophage Differentiation via SRC/LDHA Signaling in Early Pregnancy.
Effects of Fibroblast Growth Factor 21 on Lactate Uptake and Usage in Mice with Diabetes-Associated Cognitive Decline.
Simultaneous targeting of glycolysis and oxidative phosphorylation as a therapeutic strategy to treat diffuse large B-cell lymphoma.
Involvement of SLC16A1/MCT1 and SLC16A3/MCT4 in l-lactate transport in the hepatocellular carcinoma cell line.
Recurrent hypoglycemia increases hepatic gluconeogenesis without affecting glycogen metabolism or systemic lipolysis in rat.
Heat shock protein A12A activates migration of hepatocellular carcinoma cells in a monocarboxylate transporter 4-dependent manner.
Epigallocatechin‑3‑gallate hinders metabolic coupling to suppress colorectal cancer malignancy through targeting aerobic glycolysis in cancer‑associated fibroblasts.
Targeting the bicarbonate transporter SLC4A4 overcomes immunosuppression and immunotherapy resistance in pancreatic cancer.
1,25(OH)(2)D(3) alleviates LPS-induced preeclampsia-like rats impairment in the protective effect by TLR4/NF-kB pathway.
Limosilactobacillus reuteri and caffeoylquinic acid synergistically promote adipose browning and ameliorate obesity-associated disorders.
Nonylphenol inhibited HIF-1alpha regulated aerobic glycolysis and induced ROS mediated apoptosis in rat Sertoli cells.
Metformin alleviates the cognitive impairment caused by aluminum by improving energy metabolism disorders in mice.
Glycometabolic reprogramming-mediated proangiogenic phenotype enhancement of cancer-associated fibroblasts in oral squamous cell carcinoma: role of PGC-1α/PFKFB3 axis.
Anagliptin promotes apoptosis in mouse colon carcinoma cells via MCT-4/lactate-mediated intracellular acidosis.
Hypoxia Is a Dominant Remodeler of the Effector T Cell Surface Proteome Relative to Activation and Regulatory T Cell Suppression.
The lactate sensor GPR81 regulates glycolysis and tumor growth of breast cancer.
Combination of Exercise and Intake of Amino Acid Mixture Synergistically Induces Beige Adipocyte Formation in Mice.
Pharmacological Inhibition of MCT4 Reduces 4-Hydroxytamoxifen Sensitivity by Increasing HIF-1α Protein Expression in ER-Positive MCF-7 Breast Cancer Cells.
Activation of Hippocampal IR/IRS-1 Signaling Contributes to the Treatment with Zuogui Jiangtang Jieyu Decoction on the Diabetes-Related Depression.
Comprehensive Analysis of the Relationship Between Metabolic Reprogramming and Immune Function in Prostate Cancer.
Elevated Lactate by High-Intensity Interval Training Regulates the Hippocampal BDNF Expression and the Mitochondrial Quality Control System.
Activated Pancreatic Stellate Cells Enhance the Warburg Effect to Cause the Malignant Development in Chronic Pancreatitis.
Effects of endurance training on the expression of host proteins involved in SARS-CoV-2 cell entry in C57BL/6J mouse.
Basigin deficiency prevents anaplerosis and ameliorates insulin resistance and hepatosteatosis.
In vitro angiogenesis inhibition with selective compounds targeting the key glycolytic enzyme PFKFB3.
Monocarboxylate transporter antagonism reveals metabolic vulnerabilities of viral-driven lymphomas.
Lactate sensing mechanisms in arterial chemoreceptor cells.
Overexpression of monocarboxylate transporter 4 promotes the migration and invasion of non-carcinogenic L929 fibroblast cells.
Glycolysis is suppressed by DCZ0801-induced inactivation of the Akt/mTOR pathway in Multiple Myeloma.
ITGB2-mediated metabolic switch in CAFs promotes OSCC proliferation by oxidation of NADH in mitochondrial oxidative phosphorylation system.
Identification of the essential extracellular aspartic acids conserved in human monocarboxylate transporters 1, 2, and 4.
Metabolic reprogramming of normal oral fibroblasts correlated with increased glycolytic metabolism of oral squamous cell carcinoma and precedes their activation into carcinoma associated fibroblasts.
Jet-Lagged Nanoparticles Enhanced Immunotherapy Efficiency through Synergistic Reconstruction of Tumor Microenvironment and Normalized Tumor Vasculature.
Breaking Glucose Transporter 1/Pyruvate Kinase M2 Glycolytic Loop Is Required for Cantharidin Inhibition of Metastasis in Highly Metastatic Breast Cancer.
Acidic Stress Triggers Sodium-Coupled Bicarbonate Transport and Promotes Survival in A375 Human Melanoma Cells.
Homology modeling and site-directed mutagenesis identify amino acid residues underlying the substrate selection mechanism of human monocarboxylate transporters 1 (hMCT1) and 4 (hMCT4).
Tumoral microvesicle-activated glycometabolic reprogramming in fibroblasts promotes the progression of oral squamous cell carcinoma.
Prognostic value of monocarboxylate transporter 4 in patients with esophageal squamous cell carcinoma.
Overexpression of monocarboxylate anion transporter 1 and 4 in T24-induced cancer-associated fibroblasts regulates the progression of bladder cancer cells in a 3D microfluidic device.
Sakuma T, Mukai Y, Yamaguchi A, Suganuma Y, Okamoto K, Furugen A, Narumi K, Ishikawa S, Saito Y, Kobayashi M
Biological & pharmaceutical bulletin 2024;47(4):764-770
Biological & pharmaceutical bulletin 2024;47(4):764-770
Serine synthesis pathway upregulated by E-cadherin is essential for the proliferation and metastasis of breast cancers.
Lee G, Wong C, Cho A, West JJ, Crawford AJ, Russo GC, Si BR, Kim J, Hoffner L, Jang C, Jung M, Leone RD, Konstantopoulos K, Ewald AJ, Wirtz D, Jeong S
bioRxiv : the preprint server for biology 2024 Mar 26;
bioRxiv : the preprint server for biology 2024 Mar 26;
MCT4-dependent lactate transport: a novel mechanism for cardiac energy metabolism injury and inflammation in type 2 diabetes mellitus.
Ma XM, Geng K, Wang P, Jiang Z, Law BY, Xu Y
Cardiovascular diabetology 2024 Mar 14;23(1):96
Cardiovascular diabetology 2024 Mar 14;23(1):96
Real-time monitoring of glucose metabolism and effects of metformin on HepG2 cells using (13)C in-cell NMR spectroscopy.
Teng M, Li Z, Gu Y, Fan Y, Wang D, Liu M, Li Y, Wei G, Huang Y
Biochemical and biophysical research communications 2024 Jan 29;694:149383
Biochemical and biophysical research communications 2024 Jan 29;694:149383
Exercise enhances placental labyrinth trophoblast development by activation of PGC-1α and FNDC5/irisin†.
Chae SA, Du M, Zhu MJ, Son JS
Biology of reproduction 2024 Feb 10;110(2):355-364
Biology of reproduction 2024 Feb 10;110(2):355-364
Monocarboxylate transporter 4 deficiency enhances high-intensity interval training-induced metabolic adaptations in skeletal muscle.
Tamura Y, Jee E, Kouzaki K, Kotani T, Nakazato K
The Journal of physiology 2024 Apr;602(7):1313-1340
The Journal of physiology 2024 Apr;602(7):1313-1340
The SIX1/LDHA Axis Promotes Lactate Accumulation and Leads to NK Cell Dysfunction in Pancreatic Cancer.
Ge W, Meng L, Cao S, Hou C, Zhu X, Huang D, Li Q, Peng Y, Jiang K
Journal of immunology research 2023;2023:6891636
Journal of immunology research 2023;2023:6891636
Loss of Lactate/Proton Monocarboxylate Transporter 4 Induces Ferroptosis via the AMPK/ACC Pathway and Inhibition of Autophagy on Human Bladder Cancer 5637 Cell Line.
Dong S, Zheng L, Jiang T
Journal of oncology 2023;2023:2830306
Journal of oncology 2023;2023:2830306
Acidification of intracellular pH in MM tumor cells overcomes resistance to hypoxia-mediated apoptosis in vitro and in vivo.
Gastelum G, Kraut J, Veena M, Baibussinov A, Lamb C, Lyons K, Chang EY, Frost P
Frontiers in oncology 2023;13:1268421
Frontiers in oncology 2023;13:1268421
Oral administration of procyanidin B2 3,3"-di-O-gallate ameliorates experimental autoimmune encephalomyelitis through immunosuppressive effects on CD4(+) T cells by regulating glycolysis.
Endo K, Sawa T, Tanaka Y, Saiki T, Haga H, Rizeq L, Aso H, Isono M, Niitsuma F, Masaki A, Makabe H, Tanaka S
European journal of pharmacology 2023 Sep 5;954:175879
European journal of pharmacology 2023 Sep 5;954:175879
Icariin-Curcumol promotes docetaxel sensitivity in prostate cancer through modulation of the PI3K-Akt signaling pathway and the Warburg effect.
Xu W, Ding J, Kuang S, Li B, Sun T, Zhu C, Liu J, Zhu L, Li Y, Sheng W
Cancer cell international 2023 Sep 2;23(1):190
Cancer cell international 2023 Sep 2;23(1):190
Chemoproteomics reveals microbiota-derived aromatic monoamine agonists for GPRC5A.
Zhao X, Stein KR, Chen V, Griffin ME, Lairson LL, Hang HC
Nature chemical biology 2023 Oct;19(10):1205-1214
Nature chemical biology 2023 Oct;19(10):1205-1214
SETDB1 Methylates MCT1 Promoting Tumor Progression by Enhancing the Lactate Shuttle.
She X, Wu Q, Rao Z, Song D, Huang C, Feng S, Liu A, Liu L, Wan K, Li X, Yu C, Qiu C, Luo X, Hu J, Wang G, Xu F, Sun L
Advanced science (Weinheim, Baden-Wurttemberg, Germany) 2023 Oct;10(28):e2301871
Advanced science (Weinheim, Baden-Wurttemberg, Germany) 2023 Oct;10(28):e2301871
Post-ischemic inactivation of HIF prolyl hydroxylases in endothelium promotes maladaptive kidney repair by inducing glycolysis.
Tiwari R, Sharma R, Rajendran G, Borkowski GS, An SY, Schonfeld M, O'Sullivan J, Schipma MJ, Zhou Y, Courbon G, David V, Quaggin SE, Thorp E, Chandel NS, Kapitsinou PP
bioRxiv : the preprint server for biology 2023 Oct 3;
bioRxiv : the preprint server for biology 2023 Oct 3;
Evodiamine impairs HIF1A histone lactylation to inhibit Sema3A-mediated angiogenesis and PD-L1 by inducing ferroptosis in prostate cancer.
Yu Y, Huang X, Liang C, Zhang P
European journal of pharmacology 2023 Oct 15;957:176007
European journal of pharmacology 2023 Oct 15;957:176007
SLC16a6, mTORC1, and Autophagy Regulate Ketone Body Excretion in the Intestinal Cells.
Uebanso T, Fukui M, Naito C, Shimohata T, Mawatari K, Takahashi A
Biology 2023 Nov 26;12(12)
Biology 2023 Nov 26;12(12)
NPAS2 promotes aerobic glycolysis and tumor growth in prostate cancer through HIF-1A signaling.
Ma S, Chen Y, Quan P, Zhang J, Han S, Wang G, Qi R, Zhang X, Wang F, Yuan J, Yang X, Jia W, Qin W
BMC cancer 2023 Mar 28;23(1):280
BMC cancer 2023 Mar 28;23(1):280
An independent regulator of global release pathways in astrocytes generates a subtype of extracellular vesicles required for postsynaptic function.
Levy-Myers R, Daudelin D, Na CH, Sockanathan S
Science advances 2023 Jun 23;9(25):eadg2067
Science advances 2023 Jun 23;9(25):eadg2067
Nicotine activates HIF-1α and regulates acid extruders through the nicotinic acetylcholine receptor to promote the Warburg effect in non-small cell lung cancer cells.
Huang HK, Lin PC, Huang TT, Hung HY, Huang TW, Huang EY
European journal of pharmacology 2023 Jul 5;950:175778
European journal of pharmacology 2023 Jul 5;950:175778
Enhanced autophagy reversed aflatoxin B1-induced decrease in lactate secretion of dairy goat Sertoli cells.
Han S, Zhang H, Liu X, Wen F, Li B, Bie Z, Qiu H, Hu J
Ecotoxicology and environmental safety 2023 Jul 1;259:115063
Ecotoxicology and environmental safety 2023 Jul 1;259:115063
Lactylome analysis suggests lactylation-dependent mechanisms of metabolic adaptation in hepatocellular carcinoma.
Yang Z, Yan C, Ma J, Peng P, Ren X, Cai S, Shen X, Wu Y, Zhang S, Wang X, Qiu S, Zhou J, Fan J, Huang H, Gao Q
Nature metabolism 2023 Jan;5(1):61-79
Nature metabolism 2023 Jan;5(1):61-79
Lactate metabolism is essential in early-onset mitochondrial myopathy.
Chen Z, Bordieanu B, Kesavan R, Lesner NP, Venigalla SSK, Shelton SD, DeBerardinis RJ, Mishra P
Science advances 2023 Jan 4;9(1):eadd3216
Science advances 2023 Jan 4;9(1):eadd3216
Monocarboxylate transporter 4 involves in energy metabolism and drug sensitivity in hypoxia.
Yamaguchi A, Mukai Y, Sakuma T, Narumi K, Furugen A, Yamada Y, Kobayashi M
Scientific reports 2023 Jan 27;13(1):1501
Scientific reports 2023 Jan 27;13(1):1501
Immunohistochemical evaluation and prognostic value of monocarboxylate transporter 1 (MCT1) and 4 (MCT4) in T-cell non-Hodgkin lymphoma.
Zhao H, Chen Y, Liao YP, Chen HM, Yang QH, Xiao Y, Luo J, Chen ZZ, Yi L, Hu GY
Clinical and experimental medicine 2023 Feb;23(1):55-64
Clinical and experimental medicine 2023 Feb;23(1):55-64
Functional heterogeneity of MCT1 and MCT4 in metabolic reprogramming affects osteosarcoma growth and metastasis.
Sheng G, Gao Y, Wu H, Liu Y, Yang Y
Journal of orthopaedic surgery and research 2023 Feb 22;18(1):131
Journal of orthopaedic surgery and research 2023 Feb 22;18(1):131
Fibroblast growth factor 21 protects the liver from apoptosis in a type 1 diabetes mouse model via regulating L-lactate homeostasis.
Yan J, Xie J, Xu S, Guo Y, Ji K, Li C, Gao H, Zhao L
Biomedicine & pharmacotherapy = Biomedecine & pharmacotherapie 2023 Dec;168:115737
Biomedicine & pharmacotherapy = Biomedecine & pharmacotherapie 2023 Dec;168:115737
Bacterial butyrate mediates the anti-atherosclerotic effect of silybin.
Shen HR, Wang ZY, Shen Z, Liu TT, Guo YD, Gao TL, Guo HH, Han YX, Jiang JD
Biomedicine & pharmacotherapy = Biomedecine & pharmacotherapie 2023 Dec 31;169:115916
Biomedicine & pharmacotherapy = Biomedecine & pharmacotherapie 2023 Dec 31;169:115916
Circ_0000235 targets MCT4 to promote glycolysis and progression of bladder cancer by sponging miR-330-5p.
Zhong J, Xu A, Xu P, Su M, Wang P, Liu Z, Li B, Liu C, Jiang N
Cell death discovery 2023 Aug 2;9(1):283
Cell death discovery 2023 Aug 2;9(1):283
Shoutai Wan regulates glycolysis imbalance at the maternal-fetal interface in threatened abortion mice.
Zhang L, Wang S, Ma Y, Song Y, Li D, Liang X, Hao Y, Jiang M, Lv J, Du H
Journal of ethnopharmacology 2023 Aug 10;312:116502
Journal of ethnopharmacology 2023 Aug 10;312:116502
Shoutai Wan Improves Embryo Survival by Regulating Aerobic Glycolysis of Trophoblast Cells in a Mouse Model of Recurrent Spontaneous Abortion.
Liang X, Tang S, Li D, Song Y, He M, Duan Y, Du H
Evidence-based complementary and alternative medicine : eCAM 2022;2022:8251503
Evidence-based complementary and alternative medicine : eCAM 2022;2022:8251503
Trophoblast-derived Lactic Acid Orchestrates Decidual Macrophage Differentiation via SRC/LDHA Signaling in Early Pregnancy.
Gao L, Xu QH, Ma LN, Luo J, Muyayalo KP, Wang LL, Huang DH, Xiao XJ, Cheng SB, Mor G, Liao AH
International journal of biological sciences 2022;18(2):599-616
International journal of biological sciences 2022;18(2):599-616
Effects of Fibroblast Growth Factor 21 on Lactate Uptake and Usage in Mice with Diabetes-Associated Cognitive Decline.
Zhao L, Jiang H, Xie J, Shen D, Yi Q, Yan J, Li C, Zheng H, Gao H
Molecular neurobiology 2022 Sep;59(9):5656-5672
Molecular neurobiology 2022 Sep;59(9):5656-5672
Simultaneous targeting of glycolysis and oxidative phosphorylation as a therapeutic strategy to treat diffuse large B-cell lymphoma.
Noble RA, Thomas H, Zhao Y, Herendi L, Howarth R, Dragoni I, Keun HC, Vellano CP, Marszalek JR, Wedge SR
British journal of cancer 2022 Sep;127(5):937-947
British journal of cancer 2022 Sep;127(5):937-947
Involvement of SLC16A1/MCT1 and SLC16A3/MCT4 in l-lactate transport in the hepatocellular carcinoma cell line.
Mukai Y, Yamaguchi A, Sakuma T, Nadai T, Furugen A, Narumi K, Kobayashi M
Biopharmaceutics & drug disposition 2022 Oct;43(5):183-191
Biopharmaceutics & drug disposition 2022 Oct;43(5):183-191
Recurrent hypoglycemia increases hepatic gluconeogenesis without affecting glycogen metabolism or systemic lipolysis in rat.
Liu Z, Zhang L, Qian C, Zhou Y, Yu Q, Yuan J, Lv Y, Zhang L, Chang X, Li Y, Liu Y
Metabolism: clinical and experimental 2022 Nov;136:155310
Metabolism: clinical and experimental 2022 Nov;136:155310
Heat shock protein A12A activates migration of hepatocellular carcinoma cells in a monocarboxylate transporter 4-dependent manner.
Min X, Cheng H, Cao X, Chen Z, Zhang X, Li Y, Mao Q, Xue B, Fang L, Liu L, Ding Z
Cell stress & chaperones 2022 Jan;27(1):83-95
Cell stress & chaperones 2022 Jan;27(1):83-95
Epigallocatechin‑3‑gallate hinders metabolic coupling to suppress colorectal cancer malignancy through targeting aerobic glycolysis in cancer‑associated fibroblasts.
Chen S, Nishi M, Morine Y, Shimada M, Tokunaga T, Kashihara H, Takasu C, Yamada S, Wada Y
International journal of oncology 2022 Feb;60(2)
International journal of oncology 2022 Feb;60(2)
Targeting the bicarbonate transporter SLC4A4 overcomes immunosuppression and immunotherapy resistance in pancreatic cancer.
Cappellesso F, Orban MP, Shirgaonkar N, Berardi E, Serneels J, Neveu MA, Di Molfetta D, Piccapane F, Caroppo R, Debellis L, Ostyn T, Joudiou N, Mignion L, Richiardone E, Jordan BF, Gallez B, Corbet C, Roskams T, DasGupta R, Tejpar S, Di Matteo M, Taverna D, Reshkin SJ, Topal B, Virga F, Mazzone M
Nature cancer 2022 Dec;3(12):1464-1483
Nature cancer 2022 Dec;3(12):1464-1483
1,25(OH)(2)D(3) alleviates LPS-induced preeclampsia-like rats impairment in the protective effect by TLR4/NF-kB pathway.
Ma Y, Yang Y, Lv M, Zhang Y, He Q, Zhang Y, Su H, Deng X, Qian Y
Placenta 2022 Dec;130:34-41
Placenta 2022 Dec;130:34-41
Limosilactobacillus reuteri and caffeoylquinic acid synergistically promote adipose browning and ameliorate obesity-associated disorders.
Liu Y, Zhong X, Lin S, Xu H, Liang X, Wang Y, Xu J, Wang K, Guo X, Wang J, Yu M, Li C, Xie C
Microbiome 2022 Dec 15;10(1):226
Microbiome 2022 Dec 15;10(1):226
Nonylphenol inhibited HIF-1alpha regulated aerobic glycolysis and induced ROS mediated apoptosis in rat Sertoli cells.
Jiang Q, Di Q, Shan D, Xu Q
Ecotoxicology and environmental safety 2022 Aug;241:113822
Ecotoxicology and environmental safety 2022 Aug;241:113822
Metformin alleviates the cognitive impairment caused by aluminum by improving energy metabolism disorders in mice.
Song Y, Liu Z, Zhu X, Hao C, Hao W, Wu S, Yang J, Lu X, Jin C
Biochemical pharmacology 2022 Aug;202:115140
Biochemical pharmacology 2022 Aug;202:115140
Glycometabolic reprogramming-mediated proangiogenic phenotype enhancement of cancer-associated fibroblasts in oral squamous cell carcinoma: role of PGC-1α/PFKFB3 axis.
Li X, Jiang E, Zhao H, Chen Y, Xu Y, Feng C, Li J, Shang Z
British journal of cancer 2022 Aug;127(3):449-461
British journal of cancer 2022 Aug;127(3):449-461
Anagliptin promotes apoptosis in mouse colon carcinoma cells via MCT-4/lactate-mediated intracellular acidosis.
Li Q, Qin X, Kou X, Li J, Li Z, Chen C
Experimental and therapeutic medicine 2022 Apr;23(4):282
Experimental and therapeutic medicine 2022 Apr;23(4):282
Hypoxia Is a Dominant Remodeler of the Effector T Cell Surface Proteome Relative to Activation and Regulatory T Cell Suppression.
Byrnes JR, Weeks AM, Shifrut E, Carnevale J, Kirkemo L, Ashworth A, Marson A, Wells JA
Molecular & cellular proteomics : MCP 2022 Apr;21(4):100217
Molecular & cellular proteomics : MCP 2022 Apr;21(4):100217
The lactate sensor GPR81 regulates glycolysis and tumor growth of breast cancer.
Ishihara S, Hata K, Hirose K, Okui T, Toyosawa S, Uzawa N, Nishimura R, Yoneda T
Scientific reports 2022 Apr 15;12(1):6261
Scientific reports 2022 Apr 15;12(1):6261
Combination of Exercise and Intake of Amino Acid Mixture Synergistically Induces Beige Adipocyte Formation in Mice.
Kojima T, Esaki N, Tsuda T
Journal of nutritional science and vitaminology 2021;67(4):225-233
Journal of nutritional science and vitaminology 2021;67(4):225-233
Pharmacological Inhibition of MCT4 Reduces 4-Hydroxytamoxifen Sensitivity by Increasing HIF-1α Protein Expression in ER-Positive MCF-7 Breast Cancer Cells.
Nadai T, Narumi K, Furugen A, Saito Y, Iseki K, Kobayashi M
Biological & pharmaceutical bulletin 2021;44(9):1247-1253
Biological & pharmaceutical bulletin 2021;44(9):1247-1253
Activation of Hippocampal IR/IRS-1 Signaling Contributes to the Treatment with Zuogui Jiangtang Jieyu Decoction on the Diabetes-Related Depression.
Yang H, Ling J, Meng P, Liu J, Lin X, Li W, Wang Y
Evidence-based complementary and alternative medicine : eCAM 2021;2021:6688723
Evidence-based complementary and alternative medicine : eCAM 2021;2021:6688723
Comprehensive Analysis of the Relationship Between Metabolic Reprogramming and Immune Function in Prostate Cancer.
Xie W, Guo H, Zhang J, Hu L, Wu Y, Wang X
OncoTargets and therapy 2021;14:3251-3266
OncoTargets and therapy 2021;14:3251-3266
Elevated Lactate by High-Intensity Interval Training Regulates the Hippocampal BDNF Expression and the Mitochondrial Quality Control System.
Hu J, Cai M, Shang Q, Li Z, Feng Y, Liu B, Xue X, Lou S
Frontiers in physiology 2021;12:629914
Frontiers in physiology 2021;12:629914
Activated Pancreatic Stellate Cells Enhance the Warburg Effect to Cause the Malignant Development in Chronic Pancreatitis.
Tao Y, Shao F, Cai M, Liu Z, Peng Y, Huang Q, Meng F
Frontiers in oncology 2021;11:714598
Frontiers in oncology 2021;11:714598
Effects of endurance training on the expression of host proteins involved in SARS-CoV-2 cell entry in C57BL/6J mouse.
Tamura Y, Jee E, Kouzaki K, Kotani T, Nakazato K
Physiological reports 2021 Sep;9(17):e15014
Physiological reports 2021 Sep;9(17):e15014
Basigin deficiency prevents anaplerosis and ameliorates insulin resistance and hepatosteatosis.
Ryuge A, Kosugi T, Maeda K, Banno R, Gou Y, Zaitsu K, Ito T, Sato Y, Hirayama A, Tsubota S, Honda T, Nakajima K, Ozaki T, Kondoh K, Takahashi K, Kato N, Ishimoto T, Soga T, Nakagawa T, Koike T, Arima H, Yuzawa Y, Minokoshi Y, Maruyama S, Kadomatsu K
JCI insight 2021 Oct 22;6(20)
JCI insight 2021 Oct 22;6(20)
In vitro angiogenesis inhibition with selective compounds targeting the key glycolytic enzyme PFKFB3.
Abdali A, Baci D, Damiani I, Belloni F, De Dominicis C, Gelmi ML, Corsini A, Bellosta S
Pharmacological research 2021 Jun;168:105592
Pharmacological research 2021 Jun;168:105592
Monocarboxylate transporter antagonism reveals metabolic vulnerabilities of viral-driven lymphomas.
Bonglack EN, Messinger JE, Cable JM, Ch'ng J, Parnell KM, Reinoso-Vizcaíno NM, Barry AP, Russell VS, Dave SS, Christofk HR, Luftig MA
Proceedings of the National Academy of Sciences of the United States of America 2021 Jun 22;118(25)
Proceedings of the National Academy of Sciences of the United States of America 2021 Jun 22;118(25)
Lactate sensing mechanisms in arterial chemoreceptor cells.
Torres-Torrelo H, Ortega-Sáenz P, Gao L, López-Barneo J
Nature communications 2021 Jul 6;12(1):4166
Nature communications 2021 Jul 6;12(1):4166
Overexpression of monocarboxylate transporter 4 promotes the migration and invasion of non-carcinogenic L929 fibroblast cells.
Li X, Zhou X, Liu Y, Fan J, Huo H, Yao J, Wang L, Ma N
Oncology letters 2021 Jan;21(1):44
Oncology letters 2021 Jan;21(1):44
Glycolysis is suppressed by DCZ0801-induced inactivation of the Akt/mTOR pathway in Multiple Myeloma.
Feng Q, Yao Q, Li B, Xie Y, Zhang H, Xu Z, Lu K, Hu K, Cheng Y, Shi B, Huang C, Li L, Wu X, You S, Shi J, Zhu W
Journal of Cancer 2020;11(16):4907-4916
Journal of Cancer 2020;11(16):4907-4916
ITGB2-mediated metabolic switch in CAFs promotes OSCC proliferation by oxidation of NADH in mitochondrial oxidative phosphorylation system.
Zhang X, Dong Y, Zhao M, Ding L, Yang X, Jing Y, Song Y, Chen S, Hu Q, Ni Y
Theranostics 2020;10(26):12044-12059
Theranostics 2020;10(26):12044-12059
Identification of the essential extracellular aspartic acids conserved in human monocarboxylate transporters 1, 2, and 4.
Yamaguchi A, Narumi K, Furugen A, Iseki K, Kobayashi M
Biochemical and biophysical research communications 2020 Sep 3;529(4):1061-1065
Biochemical and biophysical research communications 2020 Sep 3;529(4):1061-1065
Metabolic reprogramming of normal oral fibroblasts correlated with increased glycolytic metabolism of oral squamous cell carcinoma and precedes their activation into carcinoma associated fibroblasts.
Zhang Z, Gao Z, Rajthala S, Sapkota D, Dongre H, Parajuli H, Suliman S, Das R, Li L, Bindoff LA, Costea DE, Liang X
Cellular and molecular life sciences : CMLS 2020 Mar;77(6):1115-1133
Cellular and molecular life sciences : CMLS 2020 Mar;77(6):1115-1133
Jet-Lagged Nanoparticles Enhanced Immunotherapy Efficiency through Synergistic Reconstruction of Tumor Microenvironment and Normalized Tumor Vasculature.
Jiang Z, Xiong H, Yang S, Lu Y, Deng Y, Yao J, Yao J
Advanced healthcare materials 2020 Jun;9(12):e2000075
Advanced healthcare materials 2020 Jun;9(12):e2000075
Breaking Glucose Transporter 1/Pyruvate Kinase M2 Glycolytic Loop Is Required for Cantharidin Inhibition of Metastasis in Highly Metastatic Breast Cancer.
Pan Y, Zheng Q, Ni W, Wei Z, Yu S, Jia Q, Wang M, Wang A, Chen W, Lu Y
Frontiers in pharmacology 2019;10:590
Frontiers in pharmacology 2019;10:590
Acidic Stress Triggers Sodium-Coupled Bicarbonate Transport and Promotes Survival in A375 Human Melanoma Cells.
Yang OCY, Loh SH
Scientific reports 2019 May 2;9(1):6858
Scientific reports 2019 May 2;9(1):6858
Homology modeling and site-directed mutagenesis identify amino acid residues underlying the substrate selection mechanism of human monocarboxylate transporters 1 (hMCT1) and 4 (hMCT4).
Futagi Y, Kobayashi M, Narumi K, Furugen A, Iseki K
Cellular and molecular life sciences : CMLS 2019 Dec;76(24):4905-4921
Cellular and molecular life sciences : CMLS 2019 Dec;76(24):4905-4921
Tumoral microvesicle-activated glycometabolic reprogramming in fibroblasts promotes the progression of oral squamous cell carcinoma.
Jiang E, Xu Z, Wang M, Yan T, Huang C, Zhou X, Liu Q, Wang L, Chen Y, Wang H, Liu K, Shao Z, Shang Z
FASEB journal : official publication of the Federation of American Societies for Experimental Biology 2019 Apr;33(4):5690-5703
FASEB journal : official publication of the Federation of American Societies for Experimental Biology 2019 Apr;33(4):5690-5703
Prognostic value of monocarboxylate transporter 4 in patients with esophageal squamous cell carcinoma.
Cheng B, Chen X, Li Y, Huang X, Yu J
Oncology reports 2018 Nov;40(5):2906-2915
Oncology reports 2018 Nov;40(5):2906-2915
Overexpression of monocarboxylate anion transporter 1 and 4 in T24-induced cancer-associated fibroblasts regulates the progression of bladder cancer cells in a 3D microfluidic device.
Shi H, Jiang H, Wang L, Cao Y, Liu P, Xu X, Wang Y, Sun L, Niu H
Cell cycle (Georgetown, Tex.) 2015;14(19):3058-65
Cell cycle (Georgetown, Tex.) 2015;14(19):3058-65
No comments: Submit comment
Supportive validation
- Submitted by
- Proteintech Group (provider)
- Main image

- Experimental details
- HeLa cells were subjected to SDS PAGE followed by western blot with 22787-1-AP(SLC16A3 antibody) at dilution of 1:1000
- Sample type
- cell line
Supportive validation
- Submitted by
- Proteintech Group (provider)
- Main image

- Experimental details
- The SLC16A3 antibody from Proteintech is a rabbit polyclonal antibody to a fusion protein of human SLC16A3. This antibody recognizes human antigen. The SLC16A3 antibody has been validated for the following applications: ELISA, WB, IHC, IF analysis.
Supportive validation
- Submitted by
- Proteintech Group (provider)
- Main image
- Experimental details
- Immunohistochemical of paraffin-embedded human breast cancer using 22787-1-AP(SLC16A3 antibody) at dilution of 1:50 (under 10x lens)
- Sample type
- tissue
- Submitted by
- Proteintech Group (provider)
- Main image

- Experimental details
- Immunohistochemical of paraffin-embedded human breast cancer using 22787-1-AP(SLC16A3 antibody) at dilution of 1:50 (under 40x lens)
- Sample type
- tissue